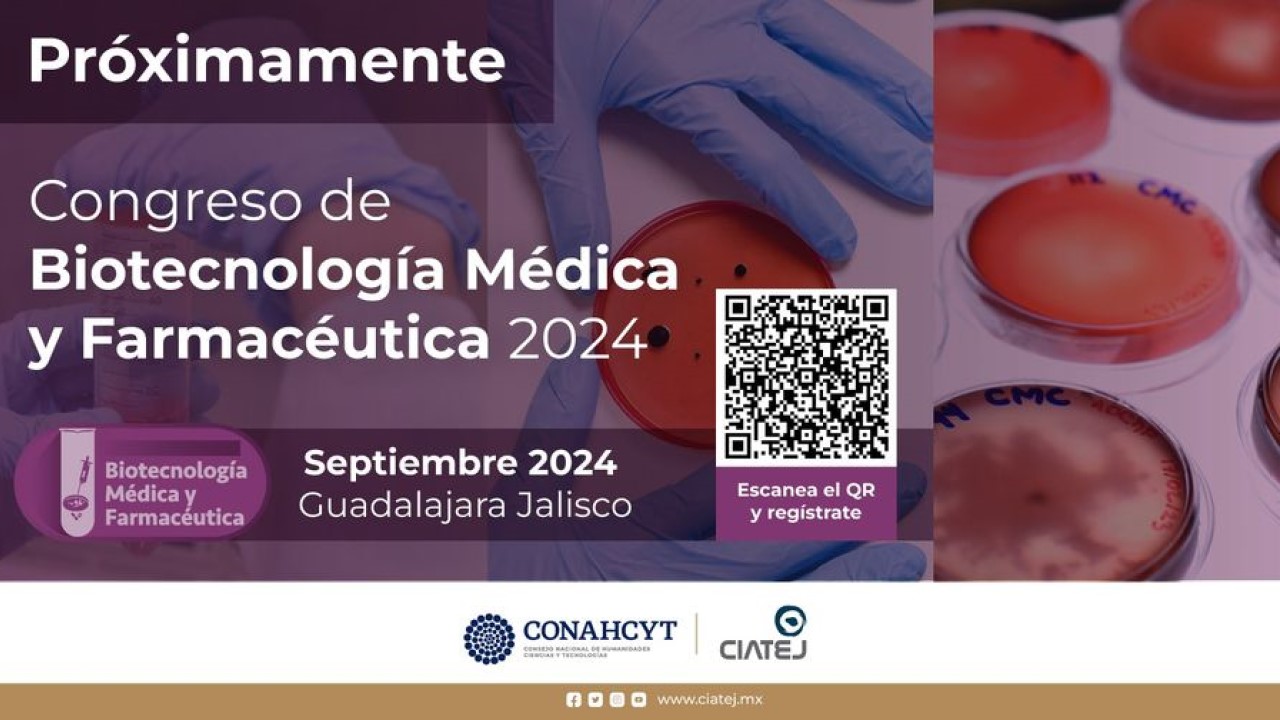
Congreso de Biotecnología Médica y Farmacéutica

Conectar
Para vincularte con el ecosistema
de emprendimiento e innovación

Para vincularte con el ecosistema
de emprendimiento e innovación

Organizado por la Asociación Jalisciense de Industrias Creativas en colaboración con CCD. Sublime Jalisco es el encuentro de negocios de las industrias creativas de la animación, efectos visuales y videojuegos.